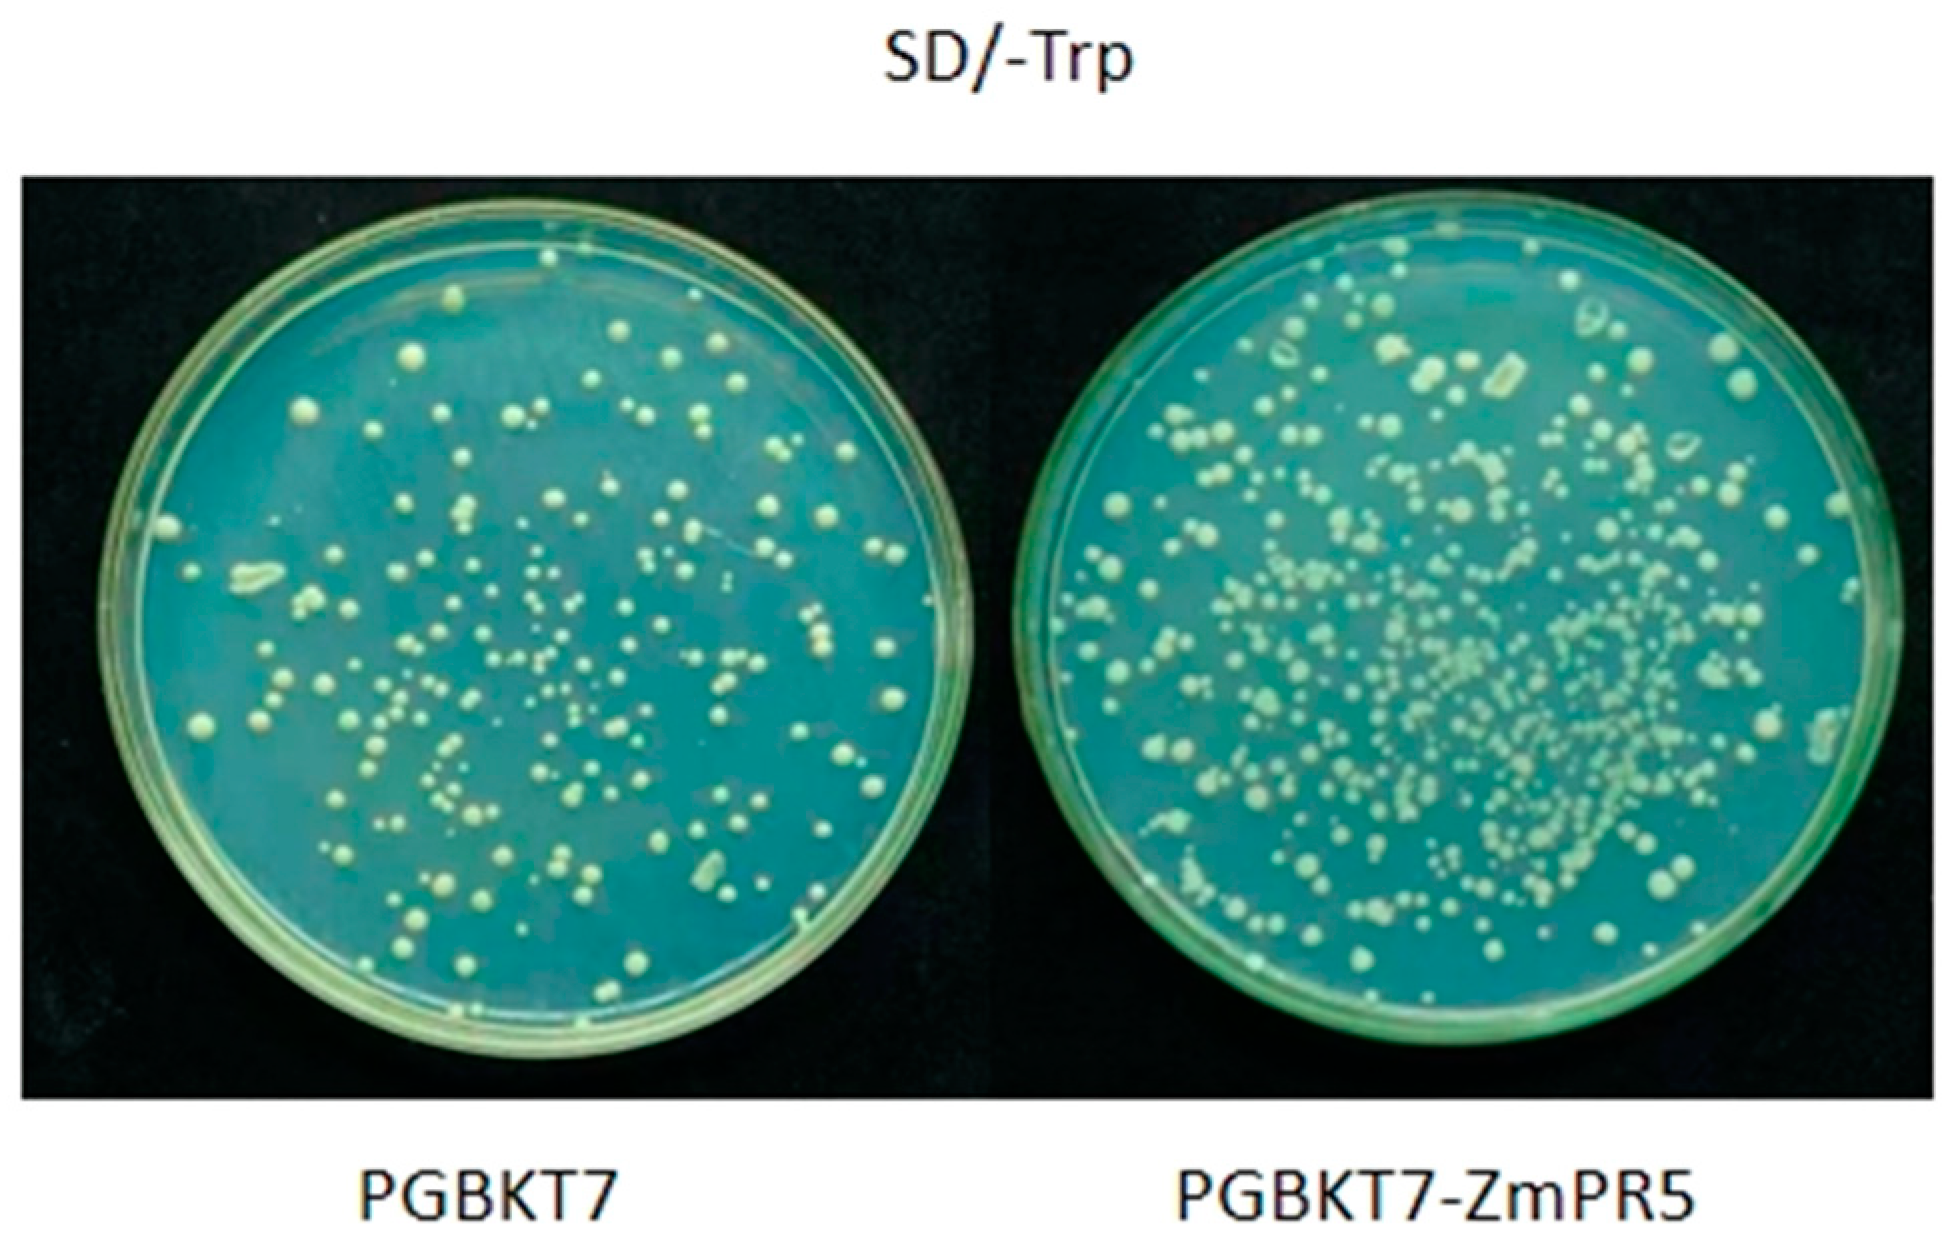
Plants 14 00737 g009
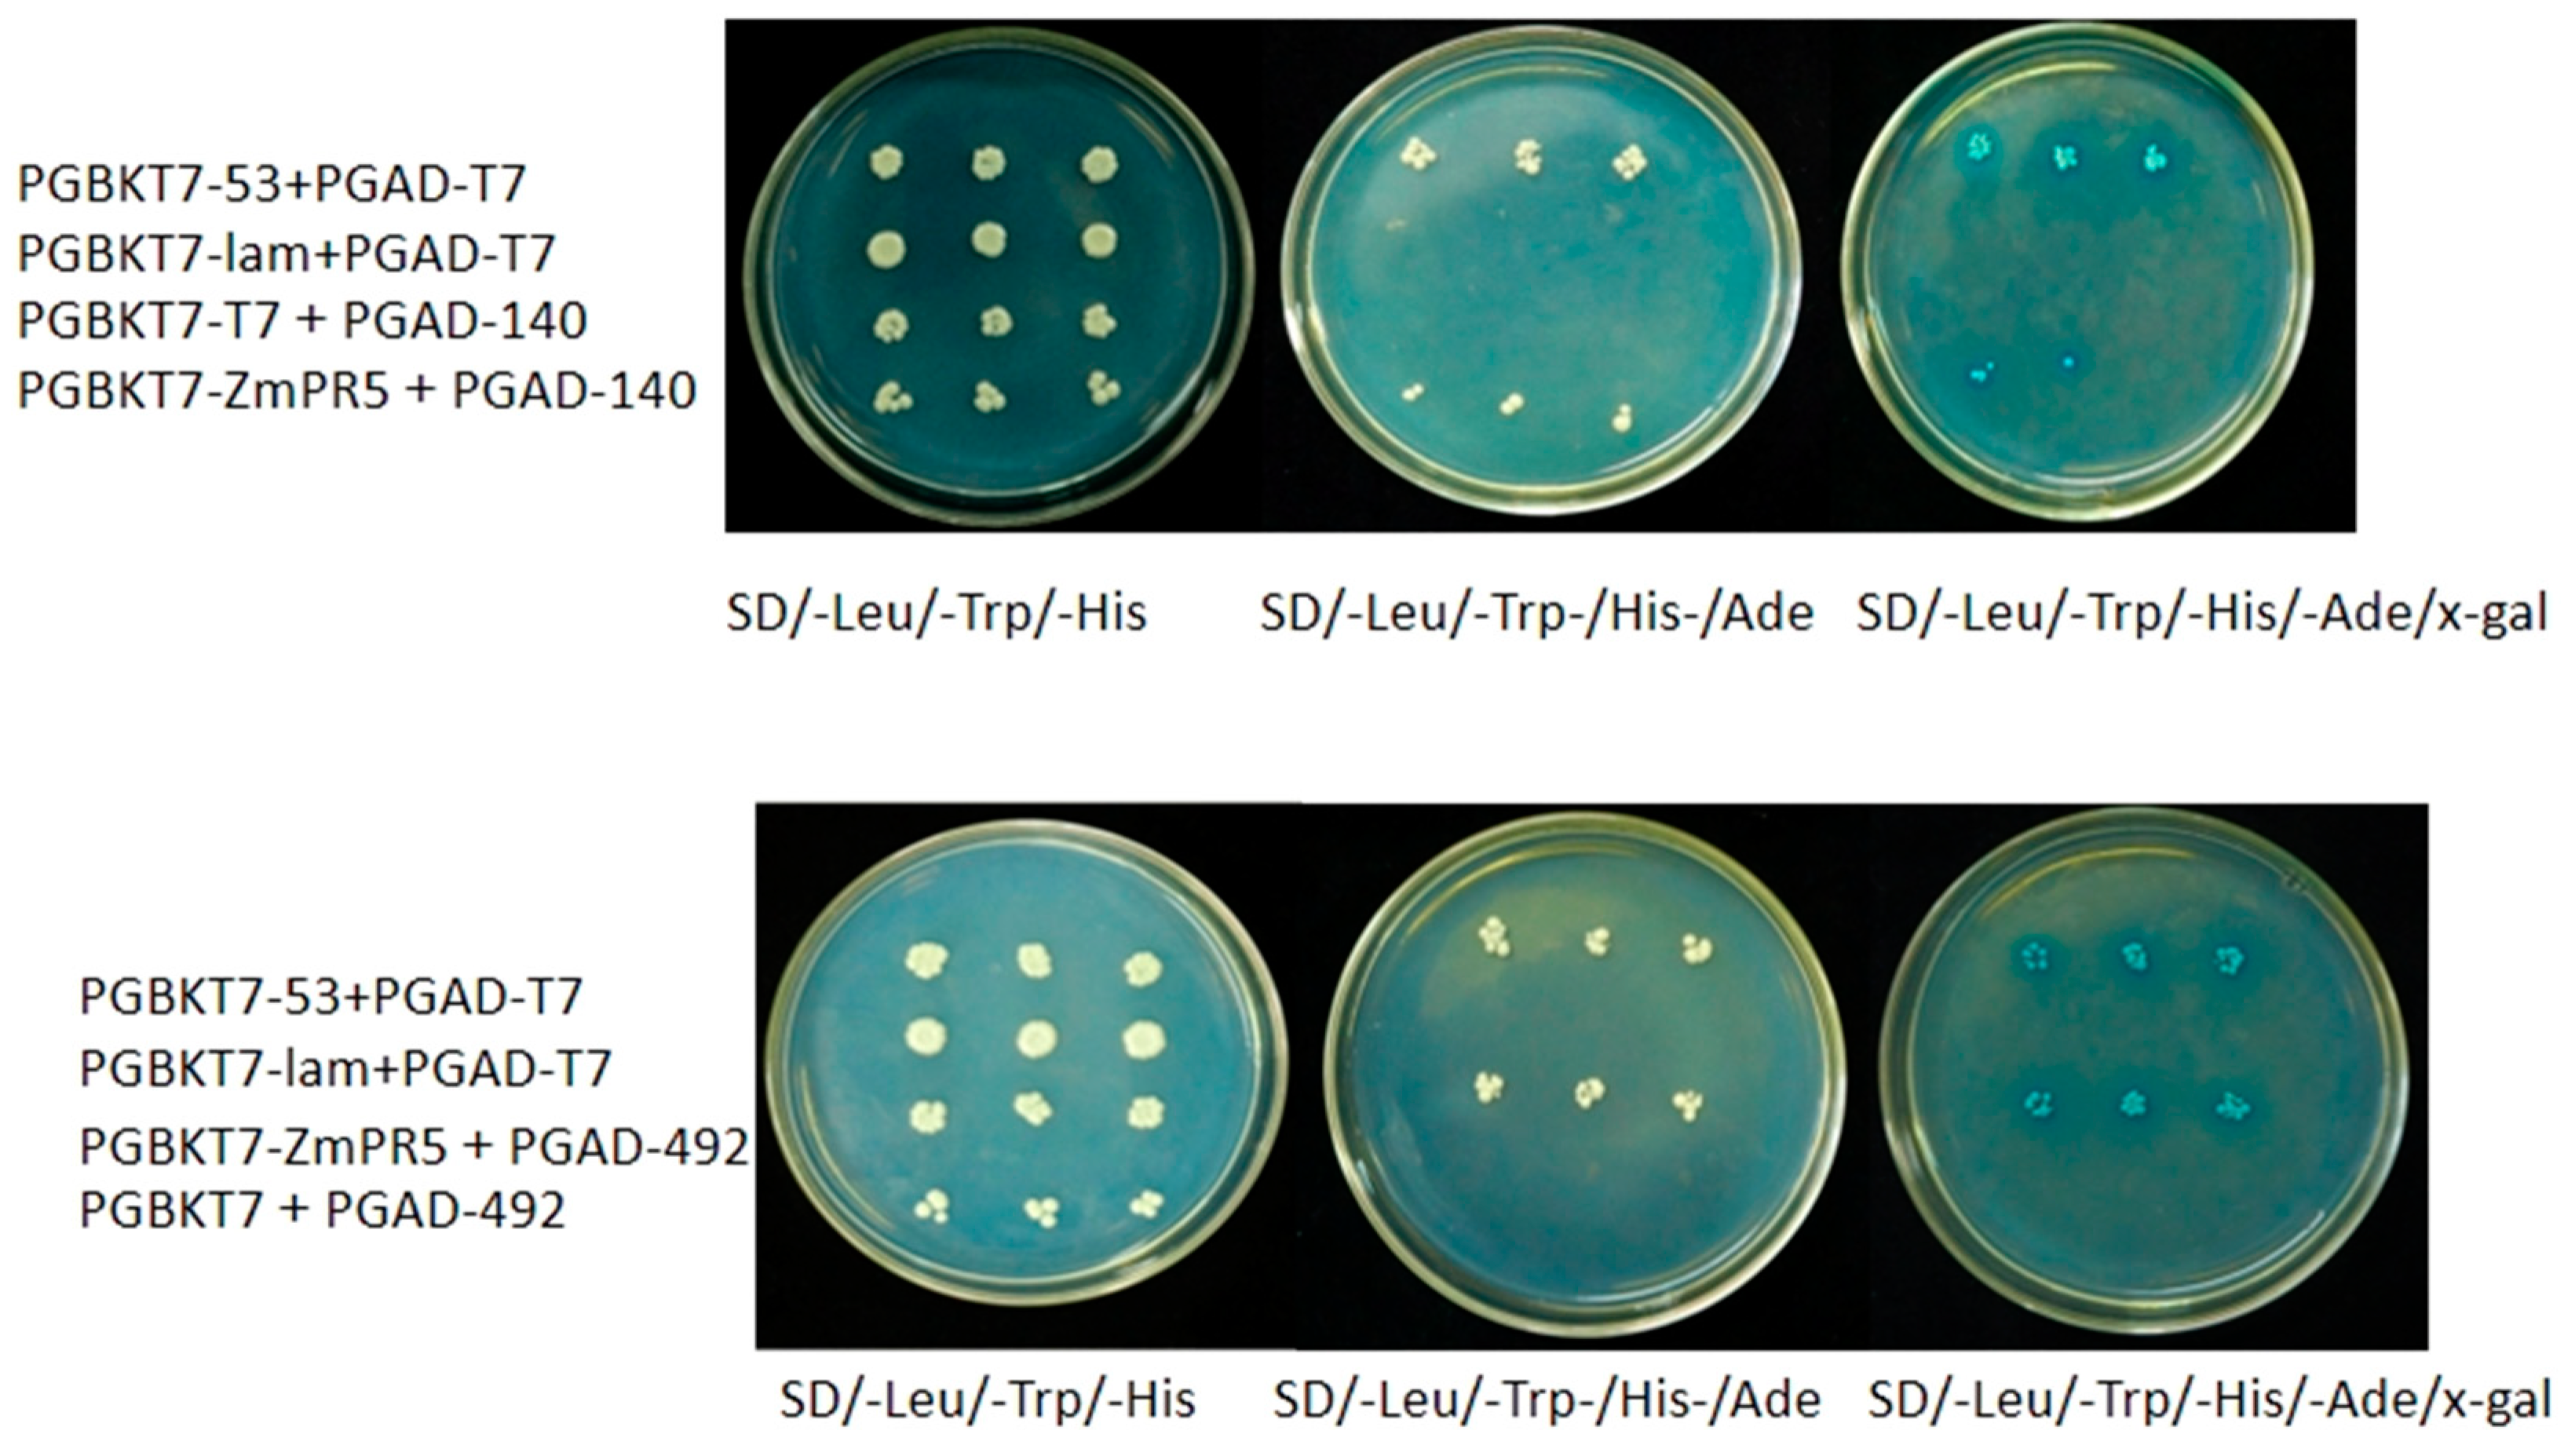
Plants 14 00737 g011

1. Introduction
Maize (
Zea mays) is one of the most important staple crops worldwide. In recent years, the frequent occurrence of severe weather conditions has increasingly exacerbated the impact of diseases on maize yield [
1]. Maize ear rot, primarily caused by fungal pathogens [
2], leads to reduced production and diminished quality of maize [
3]. It is reported that approximately 30 species of pathogens can cause maize ear rot, among which the most predominant are
Fusarium species, such as
Fusarium verticillioides, Fusarium graminearum, and
Fusarium oxysporum [
4]. Research has identified
Fusarium verticillioides as a primary pathogen responsible for ear rot in maize. This fungus can infect maize through the silk, stem, and wounds on the ear, leading to the development of ear rot in pathogen-carrying seeds [
5]. Additionally,
Fusarium verticillioides is capable of producing a significant amount of mycotoxins, known as
Fusarium mycotoxins, which include
trichothecenes,
zearalenone (ZEA), and
fumonisins (FUM), among others. These toxins contribute to the occurrence of maize ear rot [
6].
When plants are infected by pathogens, they often accumulate a class of defense proteins known as pathogenesis-related (PR) proteins [
7]. These proteins can directly attack pathogens, disrupt the macromolecules of pathogen cell walls, and degrade pathogen toxins, playing a crucial role in plant defense against pathogen invasion [
8]. Pathogenesis-related protein 5 (PR-5) belongs to the fifth family and exhibits various biological activities such as antifungal properties, β-1,3-glucanase activity, cold-resistant capabilities, and resistance to osmotic stress. PR-5 proteins are involved in the plant hypersensitive response (HR), signaling pathways, and systemic acquired resistance (SAR). Both biotic and abiotic stresses can trigger the response of PR proteins in plants [
9].
Our laboratory obtained transcriptome data by infecting the ear rot-resistant maize inbred line J1259 and selected the candidate gene PR5, which is associated with maize ear rot, for further investigation. A comprehensive functional analysis was conducted through subcellular localization, yeast two-hybrid assays, phenotypic characterization of maize mutant plants, and phenotypic evaluation of Arabidopsis over-expression lines. This study aims to provide insights into the resistance mechanisms against maize ear rot and to guide the breeding of new maize cultivars with enhanced resistance to this disease.
2. Results
2.1. Bioinformatics Analysis Results
The amino acid molecular weight of
ZmPR5 is 17,504.59 Da, with a molecular formula of C
755H
1159N
207O
245S
14, comprising a total of 174 amino acids. The theoretical isoelectric point is 4.59. Based on the instability index of 41.01, it is inferred that the
ZmPR5 protein is unstable. Hydrophobicity analysis of the amino acids encoded by the
ZmPR5 gene is illustrated, where the horizontal axis represents the amino acid sequence number and the vertical axis represents hydrophobicity. A higher value indicates greater hydrophobicity, while negative values indicate hydrophilicity. Combined with the GRAVY (Grand Average of Hydropathy) value of 0.168, it is deduced that the
ZmPR5 protein is hydrophobic (
Figure 1A).
An analysis of the conserved functional domains of the
ZmPR5 protein revealed that it contains a conserved THN domain and a signal peptide, suggesting it may localize to membrane systems, the extracellular space, or vacuoles. However, this study found that it localizes to the nucleus, suggesting the presence of a nuclear localization signal (NLS) (
Figure 1B).
ZmPR5 belongs to the PR-5 family and is a thaumatin-like protein. Several members of this family have been shown to exhibit antifungal activity by inhibiting hyphal growth in vitro, potentially through a membrane permeabilization mechanism [
10].
Through the subcellular localization prediction of ZmPR5, the probabilities were found to be nuclear 34.8%; cytoplasmic 21.7%; mitochondrial 21.7%; vesicles of the secretory system 8.7%; peroxisomal 4.3%; endoplasmic reticulum 4.3%; and vacuolar 4.3%. Therefore, the predicted result is nuclear, as this category has the highest proportion among all classifications.
In the NCBI database, homologous sequences of
ZmPR5 in other species were retrieved, and 10 sequences were obtained. The amino acid sequences of these species were compared with the
ZmPR5 protein sequence. Results showed that the
ZmPR5 protein possessed conserved domains almost identical to those of other PR proteins (
Figure 2). In the phylogenetic tree analysis conducted using MEGA (version 10.2.1) software, dark colors represent highly conserved regions, while light colors represent regions with greater variability. The results indicate that the
ZmPR5 protein is relatively conserved and shows high similarity to rice PR-5 (LOC107280997) (
Figure 3).
2.2. Subcellular Localization of ZmPR5
The constructed p1302-mgfp5-ZmPR5 vector was introduced into
Agrobacterium and injected into tobacco leaves for transient expression, with the empty p1302-mgfp5 vector serving as a control. GFP was fused to the C-terminus of the gene, and fluorescence localization was observed under a confocal microscope. The p1302-mgfp5 control showed expression in both the cell membrane and the nucleus, confirming successful infection, while the p1302-mgfp5-ZmPR5 construct exhibited green fluorescence specifically in the nucleus. The subcellular localization results indicate that
ZmPR5 is expressed in the nucleus of tobacco cells. These results are consistent with the predictions (
Figure 4).
2.3. The Impact of Over-Expressing the ZmPR5 Gene in Arabidopsis
Total RNA was extracted from seven T1-generation over-expression lines (OE1-OE7), and the Relative Expression Levels (RELs) of
ZmPR5 in each line were detected using quantitative fluorescence PCR(q-PCR). The results of the REL of
ZmPR5 in Arabidopsis showed that the OE3 group had significantly higher
ZmPR5 expression compared to the other groups. The OE1 and OE5 groups also exhibited relatively high expression levels, though lower than those of the OE3 group. Based on that, the OE1, OE3, and OE5 lines were selected for further research (
Figure 5A).
The three selected lines were cultivated to the T3 generation and were sprayed with a spore suspension of
Fusarium verticillioides when they reached the rosette stage. The RELs of
ZmPR5 and the activity of antioxidant enzymes were then measured [
11]. Ten days after infection, both the wild-type and the OE Arabidopsis plants exhibited varying degrees of wilting (
Figure 6). This study also found that
ZmPR5 is expressed in wild-type (WT) Arabidopsis, possibly due to the presence of homologous chromosomes of
ZmPR5 in Arabidopsis. By comparing WT and OE Arabidopsis before and after treatment, it is speculated that
ZmPR5 may enhance resistance to
Fusarium verticillioides.
The RELs of
ZmPR5 in the WT group were the lowest before inoculation, while the RELs in the OE1, OE3, and OE5 groups were higher with significant differences. After inoculation, the WT group still exhibited the lowest REL of
ZmPR5. The RELs in OE1, OE3, and OE5 showed significant differences compared to the WT group. Comparing pre- and post-inoculation, the RELs of
ZmPR5 increased by about 250 times on average, and significant and extremely significant differences were found in WT and OEs, respectively (
Figure 5B).
As a common model organism, Arabidopsis thaliana is widely used for the study of gene function. SOD (superoxide dismutase) is a free radical scavenger in animals and plants, capable of eliminating superoxide radicals, reducing damage to the organism, delaying the aging process, and enhancing immunity. POD (peroxidase) is widely present in plants and is associated with respiration, photosynthesis, and the oxidation of auxins. POD activity is higher in aging tissues and weaker in young tissues. CAT (catalase) can catalyze the decomposition of hydrogen peroxide into oxygen and water, and it is found in all plant tissues, representing the plant’s antioxidant capacity and self-protection ability.
MDA (malondialdehyde) is the end product of membrane lipid peroxidation. Its accumulation can cause damage to membranes and cells, and an increase in MDA content indicates that the treatment may have induced oxidative stress, causing damage to cells.
Electrical conductivity reflects the ability of a substance to transmit electric current and can indicate the integrity and permeability of cell membranes. An increase in electrical conductivity suggests that the cell membrane may be damaged, leading to increased permeability.
Chlorophyll is a key pigment in photosynthesis. A low chlorophyll content reduces the efficiency of light absorption and energy transfer, thereby weakening the plant’s photosynthetic activity.
The measurement of antioxidant enzyme activity revealed that before inoculation, there was no significant difference in SOD activity between the WT, OE1, and OE5, but a significant difference with OE3. After inoculation, SOD activity increased 2.8 times on average, and a significant difference was found between WT and OEs. Before and after inoculation, very significant differences existed between WT, OE1, and OE3 and an extremely significant difference in OE5, respectively (
Figure 7A).
There were no significant differences in POD activity between the over-expression lines and the WT. After inoculation, the POD activity increased, in particular by 3 times in OE3. Significant differences were found in WT, OE1, and OE5. A very significant difference was found in OE3 before and after inoculation (
Figure 7B).
There were significant differences in CAT activity between WT and OEs before inoculation, and OE5 had the highest CAT activity. After inoculation, WT still had the lowest CAT activity, and significant differences were observed between the WT and OEs (
Figure 7C).
Before the inoculation, there was no significant difference in MDA content between the WT group and the OE lines at the 0.05 level. After treatment, the MDA content generally increased, with the WT group showing the highest content, while the lines OE1, OE3, and OE5 had relatively lower MDA content with no significant differences among them. Comparing the pre- and post-treatment periods, there were no significant differences in MDA content in the WT, OE1, OE3, and OE5 groups after treatment (
Figure 7D).
Electrical conductivity can reflect the integrity and permeability of the cell membrane. Before or after inoculation, there were no significant differences between WT and OEs. While comparing pre- and post-inoculation, the electrical conductivity increased about 3 times, and the difference reached an extremely significant level (
Figure 8A).
Low content of chlorophyll could weaken the plant’s photosynthetic activity. Before inoculation, the chlorophyll content showed no significant differences around 1.0 mg/g. After inoculation, the WT group showed the lowest levels of chlorophyll content at 0.7 mg/g, with OE1 and OE3 showing a significant difference compared with WT. Before and after inoculation, the chlorophyll content decreased, with very significant and significant differences in WT and OE5, respectively (
Figure 8B).
2.4. ZmPR5 Interacts with WRKY53 and glucA
Constructed PGBKT7-ZmPR5 and PGBKT7 vectors were separately transformed into Y2HGold competent yeast cells and plated on SD/-Trp solid medium. Consistent growth was observed, indicating that
ZmPR5 does not exhibit toxicity (
Figure 9).
The PGBKT7-ZmPR5 and PGAD-T7 vectors were co-transformed and plated on SD/-Leu/-Trp solid medium. Colonies were then spotted onto SD/-Leu/-Trp, SD/-Leu/-Trp/-His, SD/-Leu/-Trp/-His/-Ade, and SD/-Leu/-Trp/-His/-Ade/x-gal solid media. It was observed that only the positive control (PGBKT7-53 + PGAD-T7) grew on SD/-Leu/-Trp/-His, SD/-Leu/-Trp/-His/-Ade, and SD/-Leu/-Trp/-His/-Ade/x-gal solid media, and turned blue on the SD/-Leu/-Trp/-His/-Ade/x-gal medium. In contrast, the negative control (PGBKT7-lam + PGAD-T7) and the experimental group only grew on the SD/-Leu/-Trp solid medium, indicating that
ZmPR5 does not possess self-activating activity (
Figure 10).
In gene function research, protein–protein interaction experiments can verify whether the target protein interacts with other proteins of known function, thereby inferring its potential role or involvement in biological processes.
Using the String database, potential interacting proteins of
ZmPR5 were predicted, revealing six genes that were predicted to interact with
ZmPR5,
Zm00001d017276,
Zm00001d003016,
Zm00001d003015,
Zm00001d017275,
Zm00001d020492 (
WRKY53), and
Zm00001d042140 (
glucA). Results showed that
Zm00001d020492 (
WRKY53) and
Zm00001d042140 (
glucA) formed colonies on SD/-Leu/-Trp/-His/-Ade/x-gal solid medium, indicating that
ZmPR5 interacts with
Zm00001d020492 and
Zm00001d042140 (
Figure 11).
2.5. The Impact of the Mutant ZmPR5 Gene in Maize
EMS-mutant B73 lines,
zmpr5ems1 and
zmpr5ems2, were selected based on significant differences in the RELs for
ZmPR5 compared to wild-type B73. A
Fusarium verticillioides suspension was sprayed at the three-leaf stage, and the REL of
ZmPR5 and enzyme activity were measured. After 10 days of infection, both B73 and the mutants exhibited varying degrees of lodging (
Figure 12).
Before inoculation, the RELs of
ZmPR5 in
zmpr5ems1 and
zmpr5ems
2 were lower than in WT with significant differences. After inoculation, the REL of
ZmPR5 increased in WT by 2.5 times with an extremely significant difference. It showed a significant difference compared to
zmpr5ems1 and
zmpr5ems2. No significant differences were observed before and after inoculation for REL in
zmpr5ems1 and
zmpr5ems2 (
Figure 13).
This study found that before inoculation, the SOD activity in
zmpr5ems2 was higher than WT and
zmpr5ems1, with a significant difference. After inoculation, SOD activity increased very significantly and significantly for WT and the mutants
, respectively, with the WT exhibiting the highest SOD activity: 2.5 times higher than before inoculation (
Figure 14A).
Before inoculation, the POD activity in B73 was the lowest, and there was a significant difference between WT and
zmpr5ems1. After inoculation, no significant differences in POD activity were observed. POD activity rose with only WT showing a significant difference (
Figure 14B).
The CAT activity in WT was the highest both before and after inoculation, with significant differences compared to that for
zmpr5ems1 and
zmpr5ems2. The activity of CAT increased significantly (
Figure 14C).
The MDA content bears a resemblance to the CAT activity for WT and OEs. After inoculation, the MDA content increased, and significant changes were observed (
Figure 14D).
This study found that electrical conductivity increased extremely significantly after inoculation by 2.5 times compared to before, with a significant difference between WT and
zmpr5ems1. However, before inoculation, a significant difference existed only between WT and
zmpr5ems2 (
Figure 15A).
Before inoculation, the chlorophyll content in WT was the highest, showing a significant difference with mutants. After inoculation, a significant difference still existed between WT and mutants, though chlorophyll content decreased significantly in WT (
Figure 15B).
Analysis of maize expression patterns showed a pattern of increase and decrease for
ZmPR5 RELs, and the differences were significant. Under the ABA treatment, significant differences were observed at 2H and 6H (
Figure 16A). MeJA resulted in significant differences observed at 12H, 24H, 36H, and 48H (
Figure 16B). PEG6000 led to significant differences at 2H and 6H (
Figure 16C). NaCl caused a significant difference observed at 12H. The results indicate that ABA, MeJA, PEG, and NaCl can all induce the expression of
ZmPR5 (
Figure 16D).
2.6. Maize Mutant and Trypan Blue Staining
Trypan blue is a commonly used cell viability dye. Normally, viable cells possess intact cell membranes that can exclude trypan blue, preventing it from entering the cells. In contrast, cells that have lost viability or have compromised cell membranes exhibit increased permeability, allowing trypan blue to enter. Once inside, trypan blue binds nucleic acids (DNA and RNA), forming stable complexes that stain the cells blue.
The results showed that the maize leaf was stained blue by trypan blue, indicating that the cell membranes in this region were damaged. By comparing the stained and unstained areas, it was evident that the mutant exhibits a higher degree of cell membrane damage than the wild-type maize B73, suggesting that the ZmPR5 mutant has lower resistance to
Fusarium verticillioides compared to the wild type (
Figure 17).
3. Discussion
Maize ear rot is primarily caused by
Fusarium verticillioides. In the early stages, infected kernels exhibit white, pink, or reddish-brown mycelium [
12]. As the pathogen spreads, the infected kernels typically develop pink or white streaks. The infection leads to the decay of maize kernels, and in severe cases, it can cause the maize ear to drop, thereby reducing both yield and quality [
13].
PR (Pathogenesis-Related) proteins are a class of proteins that are significantly induced and expressed during pathogen infection [
14]. PR proteins can be classified into 17 families, and most of these proteins can enhance plant resistance to pathogens [
15]. PR-5 proteins are also known as thaumatin-like proteins (TLPs) [
16]. TLPs exhibit a significant ability to inhibit the growth of pathogens [
17].
PR-5 is an important family of plant defense proteins, including osmotin and osmotin-like proteins (OLPs) that possess various stress-resistant functions and can even degrade fungal cell membranes. Some members of the PR-5 family have been demonstrated to have antifungal capabilities [
18] and activate defense responses [
19]. The tobacco PR-5 protein,
NtPR5, can strengthen the plant’s defense against further pathogen infections [
20]. Soybean PR-5 is expressed in the roots and is involved in the plant’s defense against pathogens and its response to salt stress [
21]. Phylogenetic tree analysis showed that
ZmPR5 exhibits the highest homology with rice PR-5. It is speculated that
ZmPR5 may improve resistance to
Fusarium verticillioides.
The location of a protein within the cell determines its function. This study found that
ZmPR5 is subcellularly localized in the nucleus, which is a critical site for plant immune signal transduction and the regulation of gene expression [
22].
ZmPR5 may directly participate in regulating the expression of genes related to plant immunity. This contributes to the effective functioning of
ZmPR5 in plant immune responses.
Pathogens can induce an increase in reactive oxygen species (ROS) within plants. Antioxidant enzymes protect cells from oxidative damage by scavenging ROS and free radicals, maintaining intracellular redox balance, and enhancing plant resistance to stress and pathogens [
23].
Research indicated that following Fusarium verticillioides infection, the REL of ZmPR5 in Arabidopsis OE lines is 250 times that of the wild type (WT) on average, while in maize, the WT expression is 9.5 times that of the mutant. Studies revealed that the OE1, OE3, and OE5 lines exhibited stronger antioxidant enzyme activities compared to the wild-type Arabidopsis, with SOD and POD activities significantly increased post-treatment, showing notable differences from the wild type. This suggests that the over-expression of ZmPR5 can enhance the antioxidant capacity of Arabidopsis. Furthermore, the CAT content also rose after treatment, further confirming the significant role of ZmPR5 in the antioxidant enzyme system. However, the MDA content in the OE lines is relatively lower post-treatment, with no significant difference compared to the wild type, possibly because the over-expression of the ZmPR5 gene somewhat mitigates the process of cell membrane lipid peroxidation, aiding in the defense against oxidative stress caused by pathogen infection. The changes in antioxidant enzyme activities in the mutants after Fusarium verticillioides infection also significantly differ from those in B73, with SOD and CAT activities significantly lower than in B73 post-treatment. Meanwhile, the difference in POD activity is not significant, possibly due to the different mechanisms of action of various antioxidant enzymes in the disease resistance process. The changes in MDA content further confirm the more severe cell membrane damage in the mutant, with MDA content significantly higher than in B73 post-treatment.
Studies on electrical conductivity and chlorophyll content show an increase in electrical conductivity and a decrease in chlorophyll content, while the chlorophyll content in over-expressed Arabidopsis is significantly higher than in the WT, and in maize, that in the WT is significantly higher than in the mutant. Pathogen invasion can cause cell membrane damage, leading to increased electrical conductivity, with the lack of difference possibly due to the early stage of infection or the complexity of pathogen–plant interactions [
24]. Pathogens cause the accumulation of ROS in plants, which attack chloroplast molecules, leading to chlorophyll degradation and reduced chlorophyll content [
25].
Trypan blue staining studies show that the stained areas in WT leaves are significantly smaller than in the mutant, indicating less cell membrane damage in the WT during Fusarium verticillioides infection.
Through a yeast two-hybrid assay, it was discovered that two genes,
Zm00001d020492 (
WRKY53) and
Zm00001d042140 (
glucA), interact with
ZmPR5. WRKY53 is a transcription factor involved in regulating plant disease resistance responses [
26]. The interaction with
ZmPR5 may suggest that
ZmPR5 plays a significant role in regulating the expression of disease resistance genes.
GhWRKY53 regulates cotton resistance to Verticillium wilt through the JA and SA signaling pathways [
27]. The
WRKY53 transcription factor enhances disease resistance in Chinese wild grape by interacting with
MYB14 and
MYB15 [
28].
Glutamate is a multifunctional metabolite and signaling molecule that is associated with plant growth, development, and defense responses [
29]. It is hypothesized that
ZmPR5 may establish a certain connection between sugar metabolism and disease resistance responses in plants [
30]. Through the analysis of cis-acting elements in
WRKY53 and
glucA, it was discovered that these genes possess cis-acting elements responsive to ABA, MeJA, and IAA, which may potentially activate gene expression through these regulatory elements [
31]. However, whether this gene confers resistance to
Fusarium verticillioides requires further validation. The discovery of these interacting proteins provides new clues for in-depth research into the functional mechanisms of the
ZmPR5 gene, contributing to the elucidation of its specific role in the plant disease resistance process.
Analysis of expression patterns reveals that under ABA treatment, the expression of ZmPR5 increased at 2H and 6H, with significant differences, indicating that ZmPR5 may play an important role in the ABA signaling pathway and participate in regulating plant responses to drought and other stresses. Under MeJA treatment, the expression of ZmPR5 rose at 12H, 24H, 36H, and 48H, showing significant differences, suggesting that ZmPR5 had an important role in plant defense responses and may be involved in regulating plant resistance to biotic stresses such as pathogens. PEG6000 treatment, which simulates drought stress, results in increased expression of ZmPR5 at 2H and 6H, with significant differences, further confirming its function in plant drought resistance. Under NaCl treatment, the expression of ZmPR5 increased at 12H, with significant differences, indicating that ZmPR5 also played a role in plant salt tolerance. Those results demonstrated that the ZmPR5 gene can be induced to become expressed under various stress conditions, exhibiting broad stress resistance functions.
In summary, over-expression of the ZmPR5 gene can enhance the activity of antioxidant enzymes, improve the stability of cell membranes, protect photosynthesis-related pigments, and thereby enhance the disease resistance capabilities of plants.
5. Conclusions
This study aimed to explore the role of the ZmPR5 gene in maize resistance to Fusarium verticillioides. Through experiments such as gene cloning, bioinformatics analysis, subcellular localization, over-expression in Arabidopsis thaliana, yeast two-hybrid assays, phenotypic analysis of maize mutants, and expression pattern analysis, the following conclusions were drawn: The ZmPR5 gene encodes 175 amino acids. It is an unstable hydrophobic protein containing a THN domain and a signal peptide. ZmPR5 is localized in the nucleus and shows high homology with the rice PR-5 protein. When ZmPR5 was over-expressed in Arabidopsis thaliana and inoculated with Fusarium verticillioides, the antioxidant enzyme activity of the plants was enhanced, the cell membrane stability was improved, and the chlorophyll content remained relatively stable. These results indicate that over-expressing this gene can enhance the resistance of Arabidopsis thaliana to the pathogen. In maize, after inoculation with the pathogen, the changes in relevant indicators of the zmpr5ems mutants showed that their resistance was lower than that of the wild-type B73. Trypan blue staining further confirmed that the cell membrane damage in the mutant was more severe.
Yeast two-hybrid assays showed that ZmPR5 interacts with WRKY53 and glucA, suggesting its important role in regulating the expression of disease resistance genes and the plant disease resistance process. In addition, treatments with ABA, MeJA, PEG6000, and NaCl could all induce the expression of ZmPR5, indicating that this gene has broad stress resistance functions.
In conclusion, ZmPR5 plays a crucial role in plants’ defense against Fusarium verticillioides infection. It improves plants’ tolerance to the pathogen by enhancing antioxidant capacity, maintaining cell membrane stability, and participating in disease resistance-related regulation. This study provides a basis for a deeper understanding of the molecular mechanisms of plant–pathogen interactions and offers theoretical support for breeding new maize varieties resistant to ear rot.